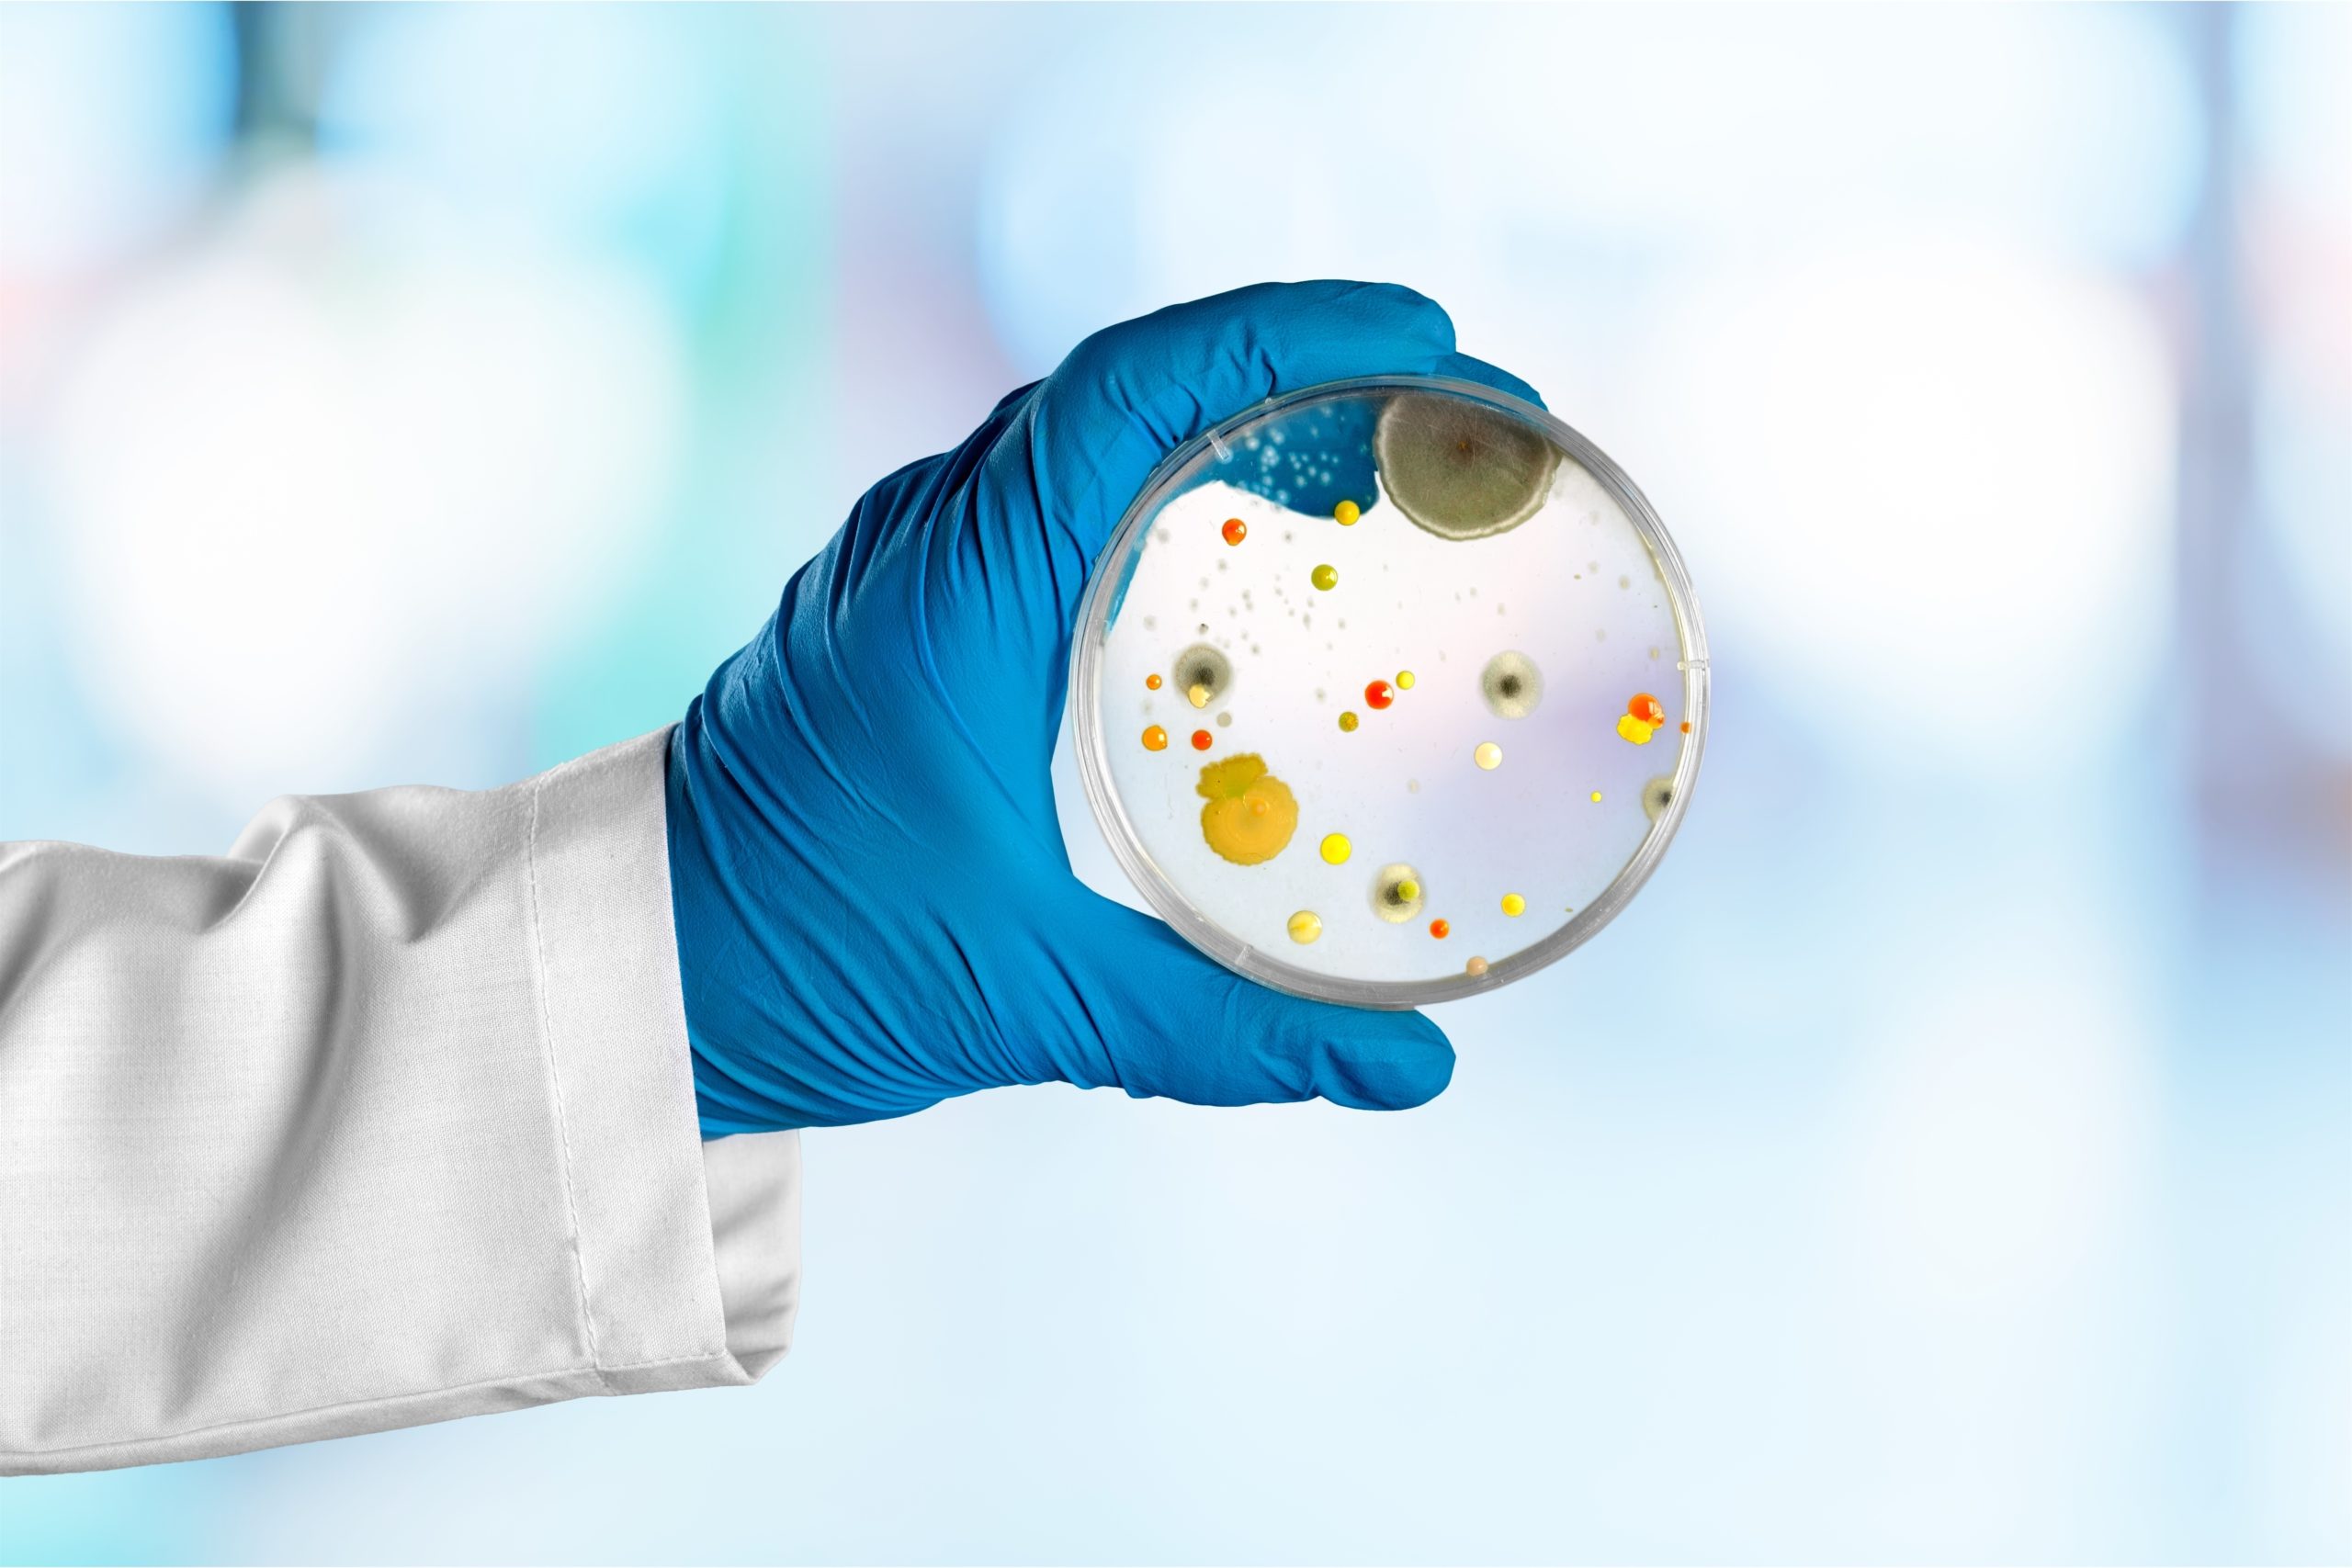

SDM Home Inspections
Your Northern California Home Inspector !
Discover the advantages of professional home inspection.
- SDM Home Inspections
I am Dedicated To Ensuring you have all of the information necessary to make an informed Home Buying Decision
Providing Home Inspections and Mold Inspections in Chico, Paradise, Magalia, Oroville, Orland, Hamilton City, Red Bluff, Yuba City

Home Inspections
From Foundation to Finish, SDM Home Inspections inspects to the InterNACHI Standard, ensuring the most complete inspection available.
Mold Inspections
Do you suspect that your home has mold? Just looking for peace of mind? Comprehensive mold inspections with IAHA Certified laboratory support are just a click away!
- Certification Really Does Matter
InterNACHI Certfied Inspector ensuring the most comprehensive inspection available.
InterNACHI® inspectors are trained and certified by the International Association of Certified Home Inspectors, the world’s largest association of residential and commercial property inspectors. InterNACHI® provides its members with accredited training and education, free benefits, expert advice, and peer support—all to help them serve their homeowner-clients with the highest-quality inspections for their largest investments.

Home Inspections
Mold Inspections

Certified Inspector
IAC2 94058
Explore Our Inspection Service Offerings
From cutting edge technology to quick report delivery, we have the inspection services and delivery infrastructure to support our clients and agents.
Thermal Imaging
Thermal imaging adds real value to a home inspection by revealing problems that can’t be seen with the naked eye. An infrared camera helps identify hidden moisture intrusion, missing or damaged insulation, electrical hot spots, and air leaks—all without invasive testing or damage to the home.
Spectora Software
Utilizing Spectora Reporting Software, which is the industry leader, allows for vivid phots of issues as well as videos.
Spectora also has a convenient Repair Request Builder for Real Estate Agents which saves time in negotiating repairs.
Mold Inspections
SDM Home Inspections provides complete Mold Inspection services with support of an EMLAP/IHLAP certified laboratory for sample processing.
We offer both air and surface sampling.
48 Hour Report Delivery
In a real estate transaction every day counts! Your report will be delivered via email within 48 business hours of your inspection.
Protecting Your Home with Certified Expertise
- Why Choose SDM Home Inspections?
With over a decade of certified service, I combine InterNACHI-compliant standards with cutting-edge inspection technology to deliver unmatched inspection services.
InterNACHI Certified
Every InterNACHI Inspector undergoes rigorous training in home inspection, including continuing education annually.
After Hours Service
Real Estate doesn't keep a 9-5 schedule, and I completely understand that! Evening, Weekend and Last Minute appointments are never a problem!


- Our Home Inspection Process
4 Simple Steps to a more informed decision
1
Schedule Your Inspection
Phone, Email, or Text consultation to assess your needs
2
On-Site Inspection
Inspection performed to InterNACHI standards
3
Client Walkthrough
We show and explain all issues found on the property
4
Printed and Online Report
Inspection documented for records or negotiation
- FAQs
Your Inspection Questions Answered by an InterNACHI Certified Inspector
I am always available to answer specific questions about my services, your home, a report I have written, or a general Inspection Question. Please Reach Out if I can help in any way.
Have another question ?
I am happy to help! Click the button below to get in touch and get your questions answered today!
What inspection services do you offer?
I offer:
-
Whole House: Complete home inspections to InterNACHI standards.
-
Mold: IAC2 Certified Mold Inspections.
-
Thermal Imaging: Identify energy loss or water intrusion.
Can I follow Along on your inspection?
Yes! It is YOUR Inspection, and if you would like to shadow me and ask questions along the way, I am happy to oblige. You will learn a great deal about your new home in the process.
Can a home FAIL Inspection?
Absolutely NOT! A home inspection is simply a snapshot in time, documenting a home’s condition. ALL homes have issues or conditions that could be corrected. I simply point these conditions out to my clients.
Can you fix it for me?
During every inspection, I find minor issues that it would be easier to repair in 1 minute than to report. However, California Business and Professional Code disallows repairs by inspectors. There is never a conflict of interest with a fully independent inspection.
How do I prepare for my appointment?
-
Clear personal belongings near the attic access
-
Ensure pets are secured
-
Note any specific concerns
- Allow plenty of time for your post-inspection walk-through
How do you bill?
Payment for service is appreciated at the time of inspection. I accept cash, check, credit/debit card and most AP-based payment methods (Zelle, Venmo, PayPal).
Escrow billing is available with a 20% surcharge.
- Blog & Articles
SDM Home Inspection Blog
Flammable Pipe Insulation Understanding Your Home Foam Pipe Insulation on Water Heaters Danger! With today’s…
Seismic Strapping Understanding Your Home How Earthquakes Can Cause Water Heater Damage Strap for Safety…
Welcome to WordPress. This is your first post. Edit or delete it, then start writing!
SDM Home Inspections provides Home Inspections throughout Northern California from Sacramento to Redding
Quick Links
Copyright © 2025 SDM Home Inspections. All Rights Reserved.



